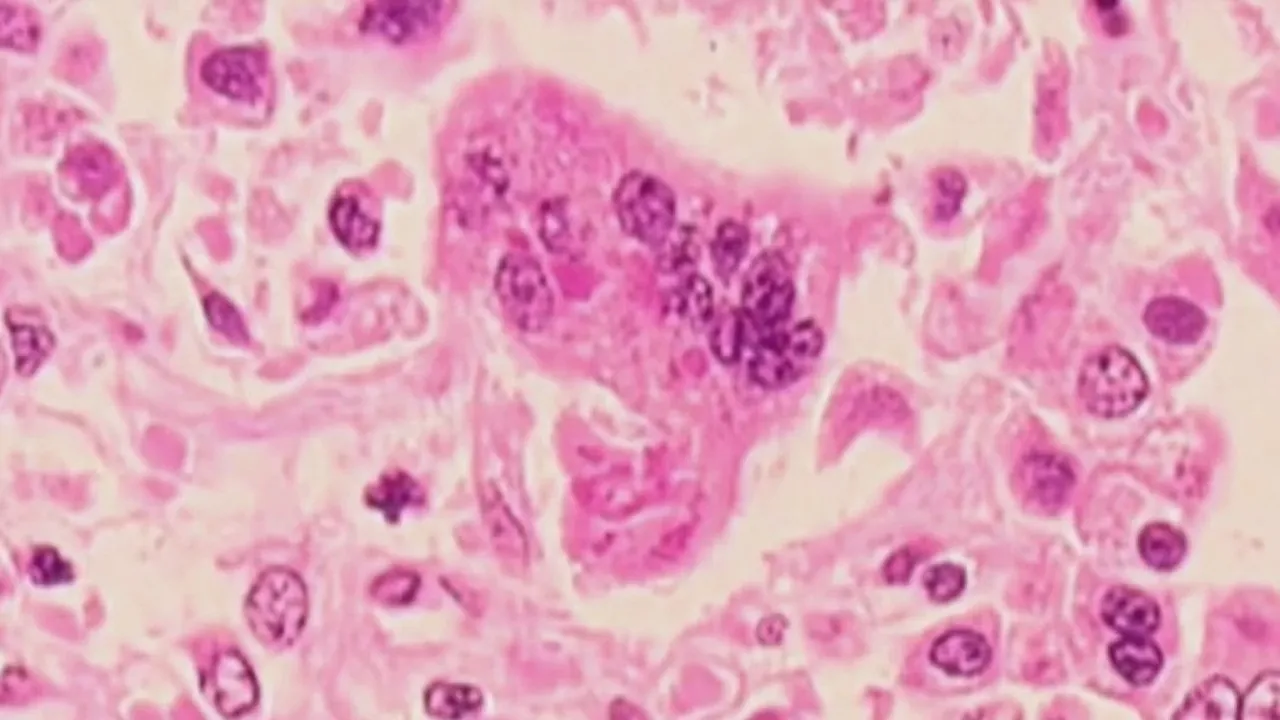

Σοκ προκάλεσε στις αρχές του Λος Άντζελες η είδηση ότι παιδί σχολικής ηλικίας έχασε τη ζωή του από μια σπάνια, αλλά γνωστή, επιπλοκή που εμφανίζεται αρκετά χρόνια μετά από λοίμωξη ιλαράς. Το παιδί είχε μολυνθεί από τον ιό στην πρώτη βρεφική ηλικία, πριν γίνει επιλέξιμο για τον εμβολιασμό.
Από τη Ρούλα Σκουρογιάννη
Το χρονικό της λοίμωξης
Σύμφωνα με το Τμήμα Δημόσιας Υγείας της Κομητείας Λος Άντζελες, το παιδί προσβλήθηκε από ιλαρά ως βρέφος, πριν από την ηλικία των 12 μηνών, δηλαδή πριν μπορέσει να λάβει το εμβόλιο MMR (ιλαρά, παρωτίτιδα, ερυθρά), το οποίο συστήνεται να χορηγείται μεταξύ 12 και 15 μηνών. Παρότι ανάρρωσε από την αρχική λοίμωξη, μερικά χρόνια αργότερα ανέπτυξε Υποξεία Σκληρυντική Πανεγκεφαλίτιδα (SSPE), μια σπάνια, προοδευτική εκφυλιστική νόσο του εγκεφάλου που μπορεί να εμφανιστεί ως απώτερη επιπλοκή της ιλαράς.
Η SSPE είναι θανατηφόρα και εξελίσσεται αργά, καταστρέφοντας σταδιακά τον εγκεφαλικό ιστό. Παρά τις προσπάθειες των γιατρών, το παιδί κατέληξε.
Πόσο συχνή είναι η SSPE
Η Υποξεία Σκληρυντική Πανεγκεφαλίτιδα είναι εξαιρετικά σπάνια: επηρεάζει περίπου 1 στις 10.000 περιπτώσεις ιλαράς. Ωστόσο, ο κίνδυνος αυξάνεται δραματικά σε βρέφη που μολύνονται πριν γίνουν επιλέξιμα για εμβολιασμό, φτάνοντας περίπου σε 1 περίπτωση ανά 600 κρούσματα, σύμφωνα με τις υγειονομικές αρχές της Κομητείας.
Η κατάσταση της ιλαράς στις ΗΠΑ
Μέχρι τις 9 Σεπτεμβρίου, τα Κέντρα Ελέγχου και Πρόληψης Νοσημάτων (CDC) έχουν καταγράψει 1.454 επιβεβαιωμένα κρούσματα ιλαράς στις ΗΠΑ το 2025, ο υψηλότερος αριθμός από το 2000. Οι περισσότερες περιπτώσεις εντοπίστηκαν στην αρχή του έτους στο Τέξας και το Νέο Μεξικό, κυρίως λόγω της πτώσης των ποσοστών εμβολιασμού στα παιδιά.
Στην Κομητεία του Λος Άντζελες έχουν αναφερθεί οκτώ κρούσματα ιλαράς σε άτομα που βρέθηκαν στην περιοχή ενώ ήταν μεταδοτικά, εκ των οποίων τέσσερις ήταν κάτοικοι της κομητείας και τέσσερις επισκέπτες.
Η ιλαρά και αξία του εμβολιασμού
Η ιλαρά είναι μία από τις πιο μεταδοτικές ιογενείς λοιμώξεις και εκτός από τον χαρακτηριστικό εξάνθημα μπορεί να οδηγήσει σε σοβαρές επιπλοκές, όπως πνευμονία, εγκεφαλίτιδα και –σε σπάνιες περιπτώσεις– την SSPE, που είναι θανατηφόρα. Το περιστατικό αυτό υπενθυμίζει τον κρίσιμο ρόλο του εμβολιασμού στην πρόληψη της νόσου και των απώτερων επιπλοκών της.
Το εμβόλιο MMR και η σημασία της συλλογικής ανοσίας
Το εμβόλιο MMR χορηγείται σε δύο δόσεις: η πρώτη μεταξύ 12 και 15 μηνών και η δεύτερη συνήθως μεταξύ 4 και 6 ετών. Η αποτελεσματικότητά του ξεπερνά το 97% μετά τη δεύτερη δόση, προσφέροντας σχεδόν πλήρη προστασία από την ιλαρά. Η ευρεία κάλυψη του πληθυσμού με εμβολιασμό δημιουργεί συλλογική ανοσία (herd immunity), που προστατεύει ακόμη και τα βρέφη που δεν έχουν φτάσει στην ηλικία εμβολιασμού ή τα άτομα που δεν μπορούν να εμβολιαστούν για ιατρικούς λόγους. Όταν τα ποσοστά εμβολιασμού πέφτουν, η συλλογική ανοσία διαταράσσεται, επιτρέποντας την επανεμφάνιση επιδημιών.
Έκκληση για εμβολιασμό
Οι υγειονομικές αρχές του Λος Άντζελες καλούν τους κατοίκους να ελέγξουν τα βιβλιάρια εμβολιασμού τους και να διασφαλίσουν ότι όλα τα μέλη της οικογένειας είναι πλήρως εμβολιασμένα. Ιδιαίτερη προσοχή συστήνεται σε όσους πρόκειται να ταξιδέψουν σε περιοχές με ενεργές εστίες ιλαράς.
Διεθνής διάσταση: Η κατάσταση εμβολιαστικής κάλυψης στην Ευρώπη
Στην Ευρώπη και την περιοχή της Κεντρικής Ασίας παρατηρούνται ανησυχητικές τάσεις όσον αφορά τον εμβολιασμό κατά της ιλαράς. Σύμφωνα με τα στοιχεία του WHO και της UNICEF, το 2024 η περιοχή κατέγραψε 127.350 κρούσματα ιλαράς, διπλάσια από τα αντίστοιχα του 2023, και ο υψηλότερος αριθμός από το 1997. Πάνω από το 40% των κρουσμάτων αφορούσε παιδιά κάτω των 5 ετών, και σε πολλές χώρες το ποσοστό εμβολιασμού για την πρώτη δόση του εμβολίου MMR έχει πέσει πολύ κάτω από το απαιτούμενο όριο για την επίτευξη της συλλογικής ανοσίας.
Κάποιες χώρες παρουσιάζουν ιδιαίτερα χαμηλά ποσοστά: για παράδειγμα, στη Ρουμανία το ποσοστό εμβολιασμού με την πρώτη δόση (MMR1) είναι γύρω στο 62%, ενώ για τη δεύτερη δόση η κάλυψη έχει επίσης πέσει σημαντικά. Σε ολόκληρη την Ευρωπαϊκή Ένωση / Οικονομική Ζώνη ΕΕ/ΕΟΧ, μόνο λίγες χώρες –όπως η Ουγγαρία, η Μάλτα, η Πορτογαλία και η Σλοβακία– πλησιάζουν ή υπερβαίνουν το 95% κάλυψης με δύο δόσεις MMR, που θεωρείται το όριο για αποτελεσματική συλλογική ανοσία.
Όπως τονίζει ο Παγκόσμιος Οργανισμός Υγείας, η πτώση των ποσοστών εμβολιασμού μετά την περίοδο της πανδημίας COVID-19, η διασπορά παραπληροφόρησης, αλλά και οι διαφορές στην πρόσβαση σε υπηρεσίες υγείας σε απομακρυσμένες ή κοινωνικά υποβαθμισμένες περιοχές συμβάλλουν στην αύξηση των κρουσμάτων.